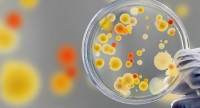

На Закарпатті у 28 працівників їдалень виявили стафілокок
У 28 працівників харчоблоків закладів освіти Закарпаття виявили золотистий стафілокок. Це 5,6?% від загальної кількості протестованих, — розповіла Cуспільному заступниця генерального директора Закарпатського обласного центру контролю та профілактики хвороб Тетяна Літовченко.